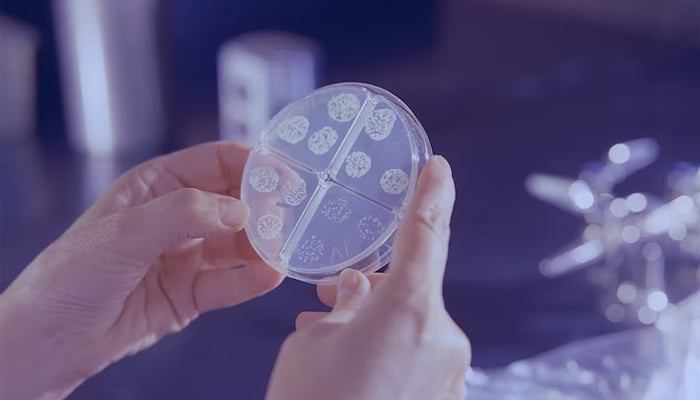

Florida’da et yiyen 5 bakteriyi öldürür. Güvende kalmak için bilmeniz gerekenler
ABD’li yetkililer, yaz süresince Florida, New York ve Connecticut’ta Vibrio vulnificus adlı yeni, et yiyen bir bakteriden minimum sekiz kişinin öldüğünü doğruladı.
Florida Sıhhat Departmanına nazaran, bu yıl kümülatif olarak bu bakterinin 26 vakası bildirildi ve iki ölümün Tampa’nın evi olan Hillsboro İlçesinde, üçünün de Pasco, Polk ve Sarasota ilçelerinde bulunduğunu kaydetti.
New York Valisi Kathy Hochul yapmış olduğu açıklamada, “Ender de olsa Vibrio bakterisi maalesef bu bölgeye ulaştı ve oldukça tehlikeli olabilir” dedi.
Connecticut Halk Sağlığı Departmanı geçen ay üç kişiye et yiyen bakteri bulaştığını söylemiş oldu. Üç kurbanın yaşları 60 ile 80 içinde değişiyordu ve ölümler Temmuz ayında meydana geldi.
ABD basınında çıkan haberlere nazaran, geçen ay üç Şimal Karolina sakini ılık deniz suyu ve tuzlu suda bulunan bakteriler sebebiyle yaşamını yitirdi.
the Amerikan Tabipler Birliği Dergisi ABD Birleşik Devletleri’nde her yıl ortalama 100 Vibrio vakasının bildirildiğini, sadece hafifçe enfeksiyon sebebiyle insanlara kontrol yapılmadığını ve bundan dolayı kati sayının bilinmediğini ihmal etmeyin.
Bu bakterilerden meydana gelen enfeksiyon ek olarak, Hastalık Denetim ve Önleme Merkezlerinin (CDC) “vücudun açık bir yara çevresinde öldüğü ciddi bir enfeksiyon” olarak tanımladığı nekrotizan fasiite neden olur.
Kendinizi et yiyen bakterilerden iyi mi korursunuz?
Vali Hochul’a nazaran, halk “kendilerini ve sevdiklerini güvende tutmak için uyanık olmalı ve görevli önlemler almalıdır.” Açık yaraları deniz suyundan korumayı ve bağışıklık sistemi zayıf olanlara önerdi. Ek olarak insanlara azca pişmiş kabuklu deniz hayvanlarından uzak durmalarını tavsiye etti.
HKM’ye nazaran:
- Pişmeden istiridyeleri teslim ettikten sonrasında ellerinizi sudan geçirin
- Pişmiş kabuklu deniz hayvanlarını pişmemiş kabuklu deniz ürünleri ve suları ile kirletmekten kaçının
- Deniz suyuna yada pişmemiş deniz ürünlerine yada bunların sularına maruz kalmışlarsa kesikleri ve yaraları iyice sudan geçirin.
CDC internet sayfasında ek olarak şu şekilde belirtiliyor: “Bir cilt enfeksiyonu geliştirirseniz, cildiniz tuzlu su, tuzlu su, pişmemiş deniz ürünleri yada pişmemiş deniz ürünleri suları ile temas ederse tıbbi sağlayıcınıza açıklayın.”
Et yiyen bakterilerin emareleri nedir?
CDC, kramplı ishali, mide bulantısını, kusmayı ve ateşi içerebilen çeşitli semptomlar bulunduğunu belirtiyor.
Bir kan dolaşımı enfeksiyonu için semptomlar şunları ihtiva eder:
- Ateş
- tüylerim diken diken
- Düşük tansiyon
- kabarcıklı cilt lezyonları
- kırmızılık
- ağrı
- şişme
- ısı
- renklenme
- Drenaj yada sıvı sızıntısı
CDC ek olarak şunları da belirtti: Bir kişinin yarasında, kanında yada dışkısında Vibrio bakterisi bulunduğunda ve antibiyotiklerle tedavi edildiğinde bir enfeksiyon teşhis edilir.
“Doktorların, ölü yada enfekte olmuş dokuyu çıkarmak için bir hastanın bacaklarını yada kollarını kesmesi gerekebilir.”